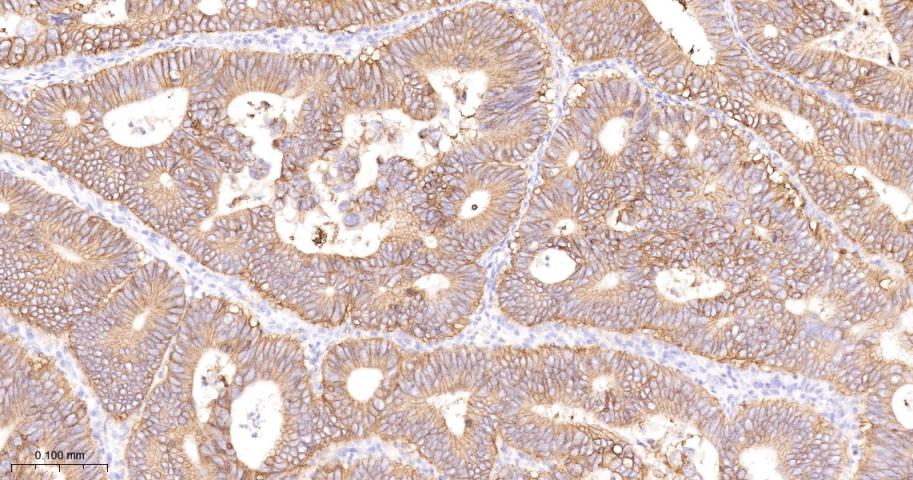
CD46重组兔多克隆抗体

CD46重组兔多克隆抗体
Rrmab?兔单抗

货号:bsm-54335R
产品详情
相关标记
相关产品
相关文献
常见问题
概述
产品编号
bsm-54335R
产品类型
重组兔单抗
英文名称
CD46 Recombinant Rabbit mAb
中文名称
CD46重组兔多克隆抗体
英文别名
Mcp; AHUS2; MIC10; TLX; TRA2.10; MCP_HUMAN; CD46; Trophoblast leukocyte common antigen; MCP_MOUSE; MCP_RAT;
抗体来源
Rabbit
免疫原
A synthesized peptide derived from human CD46: 30-87
亚型
IgG
性状
Liquid
纯化方法
affinity purified by Protein A
克隆类型
Recombinant
克隆号
4C3
理论分子量
36 kDa
浓度
1mg/ml
储存液
0.01M TBS (pH7.4) with 1% BSA, 0.02% Proclin300 and 50% Glycerol.
研究领域
SWISS
Gene ID
保存条件
Shipped at 4℃. Store at -20℃ for one year. Avoid repeated freeze/thaw cycles.
注意事项
This product as supplied is intended for research use only, not for use in human, therapeutic or diagnostic applications.
数据库链接
产品介绍
MCP为一单链穿膜糖蛋白,是补体系统的一种新的调节蛋白,是内源性辅助因子活性蛋白,属于RCA基因簇的成员。CD46通过GPI锚固定于细胞上。MCP的细胞分布广范,在粒细胞、血小板、T细胞(Th、Ts、Tc)、B细胞、NK细胞、造血细胞系、成纤维细胞、表皮细胞、内皮细胞及星状胶质细胞等都有分布。
背景资料
CD46 is one of the membrane complement regulatory proteins. CD46 possesses C3b-binding and factor I cofactor activities which play important roles in the regulation of the complement activation pathway. CD46 is widely distributed on blood cells, endothelial cells, epithelial cells and tumor cell lines. CD46 exists as many isoforms in a variety of tissues. The antigen has a broad distribution and is present on leukocytes, platelets, endothelial cells, epithelial cells and fibroblasts. It is strongly expressed on salivary gland ducts and kidney ducts, moderately on lymphocytes and endothelium, and weakly on interstitial tissues and muscle cells, but not on erythrocytes. It is expressed on thymocytes, B cells, monocytes, granulocytes, NK cells, platelets, epithelial and endothelial cells.

产品应用
| 应用 | 已检合格种属 | 预测种属 | 推荐稀释比例 |
|---|---|---|---|
| WB | Human | 1:500-2000 | |
| IHC-P | Human | 1:100-500 | |
| IHC-F | Human | 1:100-500 | |
| IF | Human | 1:100-500 | |
| ICC/IF | Human | 1:50-200 |
交叉反应
交叉反应: Human
相关产品
暂无相关产品
靶标
基因名
CD46
蛋白名
Membrane cofactor protein
亚基
Interacts with C3b and C4b. Binds to Measles virus H protein, to Human herpesvirus 6 GH protein and to human adenovirus B/D PIV/fiber protein, and acts as a receptor for these viruses. Binds to Streptococcus pyogenes M protein and to type IV pili from Neisseria, and may act as a receptor for these pathogenic bacteria.
亚细胞定位
Isoform 1: Cytoplasmic vesicle, secretory vesicle, acrosome inner membrane; Single-pass type I membrane protein. Note=Inner acrosomal membrane of spermatozoa.
Isoform 2: Secreted (Probable).
Isoform 2: Secreted (Probable).
组织特异性
Present only in testis (at protein level).
翻译后修饰
May be O-glycosylated (By similarity).
N-glycosylated.
N-glycosylated.
疾病
Defects in CD46 are a cause of susceptibility to hemolytic uremic syndrome atypical type 2 (AHUS2) [MIM:612922]. An atypical form of hemolytic uremic syndrome. It is a complex genetic disease characterized by microangiopathic hemolytic anemia, thrombocytopenia, renal failure and absence of episodes of enterocolitis and diarrhea. In contrast to typical hemolytic uremic syndrome, atypical forms have a poorer prognosis, with higher death rates and frequent progression to end-stage renal disease. Note=Susceptibility to the development of atypical hemolytic uremic syndrome can be conferred by mutations in various components of or regulatory factors in the complement cascade system. Other genes may play a role in modifying the phenotype. Patients with CD46 mutations seem to have an overall better prognosis compared to patients carrying CFH mutations.
相似性
Contains 4 Sushi (CCP/SCR) domains.
功能
May be involved in the fusion of the spermatozoa with the oocyte during fertilization.
标记抗体
暂无标记数据
同靶标产品
暂无同靶标产品
相关文献
提示: 发表研究结果有使用 bsm-54335R 时请让我们知道,以便我们可以引用参考文章。作为回馈,资料提供者将获得我们送上的小礼品。
暂无相关文献
常见问题
暂无常见问题